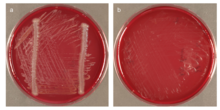
Description de l'image Phylum-Chloroflexi-isolate-Anaerolineae-bacterium-HOT-439-is-dependent-on-a-helper-strain.png.

Chloroflexota

| Domaine | Bacteria |
|---|
Embranchement
Synonymes
- Chloroflexota Whitman et al. 2018
- Chloroflexaeota Oren et al. 2015
- Chlorobacteria Cavalier-Smith 2006
- Eobacteria Cavalier-Smith 2002
- Chloroflexi Garrity & Holt 2001
Les Chloroflexota – anciennement Chlorobacteria (en français les Chlorobactéries) – forment un embranchement (ou phylum, ou encore division) du règne des Bacteria. Son nom provient de Chloroflexus qui est le genre type de cet embranchement.
Certains auteurs pensent que ce phylum pourrait être l'un des plus anciens existant encore.
Historique
Thomas Cavalier-Smith a fait du phylum Chlorobacteria un des phylums de sa classification[2]. Il est possible que ce soit l'embranchement bactérien le plus ancien qui existe encore à l'heure actuelle[3] : la racine de l'arbre du vivant pourrait donc se trouver parmi les chlorobactéries ou bien entre les chlorobactéries et le reste du vivant.
Les chlorobactéries tirent leur nom du genre Chloroflexus, qui a lui-même donné son nom à la classe des Chloroflexi. Les chlorobactéries possèdent des métabolismes variés même si le plus typique est la photohétérotrophie anoxygénique des chloroflèxes. En 2021, Oren et Garrity rectifient la nomenclature des phyla bactérien et parmi ceux-ci celui des chlorobactéries qui deviennent les Chloroflexota[1].
Taxonomie
Étymologie
L'étymologie de ce phylum Chloroflexota est la suivante : Chlo.ro.fle.xo’ta N.L. masc. n. Chloroflexus, genre type de ce phylum; N.L. neut. pl. n. suff. -ota, suffixe pour définir un phylum; N.L. neut. pl. n. Chloroflexota, le phylum des Chloroflexus[1],[4].
Liste des classes
Selon la LPSN (11 novembre 2022)[5] :
- Anaerolineae Yamada et al. 2006
- Ardenticatenia Kawaichi et al. 2013
- Caldilineae Yamada et al. 2006
- Chloroflexia corrig. Gupta et al. 2013
- Dehalococcoidia Löffler et al. 2013
- Ktedonobacteria corrig. Cavaletti et al. 2007
- Tepidiformia Kochetkova et al. 2020
- Thermoflexia Dodsworth et al. 2014
Liste des Candidatus
Selon la LPSN (11 novembre 2022)[5], plusieurs classes n'ont pas été publiées de manière valide et sont en attente de validation:
- "Candidatus Bathosphaeria" Mehrshad et al. 2018
- "Candidatus Limnocylindria" Mehrshad et al. 2018
- "Candidatus Thermofontia" corrig. Ward et al. 2018
- "Candidatus Umbricyclopia" Mehrshad et al. 2018
Controverse sur leur structure
Les chlorobactéries sont traditionnellement considérées comme des bactéries Gram négative à structure bimembranée. Il semblerait pourtant que certains membres aient une structure unimembranée[6], ce qui jette le doute sur la monophylie de ce taxon.
Position phylogénétique supposée
| |||||||||||||||||||||||||||||||||||||||||||||||||||||||||||||||||||
Classification
‘Candidatus Chlorothrix’♠
- ‘Candidatus Chlorothrix halophila’♠
Classe Anaerolineae
- Anaerolineales
- Anaerolineaceae
- Anaerolinea
- A. thermolimosa
- A. thermophila
- Bellilinea
- Bellilinea caldifistulae
- Leptolinea
- Leptolinea tardivitalis
- Levilinea
- Levilinea saccharolytica
- Longilinea
- Longilinea arvoryzae
- Anaerolinea
- Anaerolineaceae
- Caldilineales
- Caldilineaceae
- Caldilinea
- C. aerophila
- C. tarbellica♠
- Caldilinea
- Caldilineaceae
Classe Chloroflexi
- Kouleothrix♠
- Kouleothrix aurantiaca♠
- Chloroflexales
- Dehalobium♠
- Dehalobium chlorocoercia♠
- Chloroflexaceae
- Chloroflexus
- C. aggregans
- C. aurantiacus
- Chloronema
- Chloronema giganteum
- Heliothrix
- Heliothrix oregonensis
- Roseiflexus
- Roseiflexus castenholzii
- Chloroflexus
- Oscillochloridaceae
- Oscillochloris
- O. chrysea
- O. trichoides
- Oscillochloris
- Dehalobium♠
- Herpetosiphonales
- Herpetosiphonaceae
- Herpetosiphon
- H. aurantiacus
- H. geysericola
- Herpetosiphon
- Herpetosiphonaceae
Classe Dehalococcoidetes
- Dehalococcoides♠
- Dehalococcoides ethenogenes♠
- Dehalogenimonas♠
- Dehalogenimonas lykanthroporepellens ♠
Classe Ktedonobacteria
- Ktedonobacterales
- Ktedonobacteraceae
- Ktedonobacter
- Ktedonobacter racemifer
- Ktedonobacter
- Thermosporotrichaceae
- Thermosporothrix
- Thermosporothrix hazakensis
- Thermosporothrix
- Ktedonobacteraceae
- Thermogemmatisporales
- Thermogemmatisporaceae
- Thermogemmatispora
- T. foliorum♠
- T. onikobensis♠
- Thermogemmatispora
- Thermogemmatisporaceae
Classe Thermomicrobia
- Thermobaculum♠
- Thermobaculum terrenum♠
- Thermomicrobiales
- Thermomicrobiaceae
- Thermomicrobium
- Thermomicrobium roseum
- Thermomicrobium
- Thermomicrobiaceae
- Sphaerobacterales
- Sphaerobacteraceae
- Sphaerobacter
- Sphaerobacter thermophilus
- Sphaerobacter
- Sphaerobacteraceae
Note: ♠ Strain found at the National Center for Biotechnology Information (NCBI) but not recognised by List of Prokaryotic names with Standing in Nomenclature (LPSN) or published by International Journal of Systematic and Evolutionary Microbiology (IJSB/IJSEM).
Notes et références
- 1 2 3 Oren et Garrity 2021, p. 3.
- ↑ Thomas Cavalier-Smith, 1998. A revised six-kingdom system of life. Biol. Rev. 73: 203-266.
- ↑ Thomas Cavalier-Smith, 2006. Rooting the tree of life by transition analyses. Biol Direct. ; 1: 19. doi: 10.1186/1745-6150-1-19
- ↑ (en) « Phylum Chloroflexota », sur LPSN - List of Prokaryotic names with Standing in Nomenclature (consulté le ).
- 1 2 List of Prokaryotic names with Standing in Nomenclature (LPSN), consulté le 11 novembre 2022.
- ↑ (en) Iain C. Sutcliffe, « A phylum level perspective on bacterial cell envelope architecture », Trends in Microbiology, vol. 18, no 10, , p. 464-470 (DOI 10.1016/j.tim.2010.06.005).
Bibliographie
- (en) A Oren et GM Garrity, « Valid publication of the names of forty-two phyla of prokaryotes », Int J Syst Evol Microbiol, vol. 71, no 10, , p. 005056 (DOI 10.1099/ijsem.0.005056)
Liens externes
- Ressources relatives au vivant :
- Portail de la microbiologie